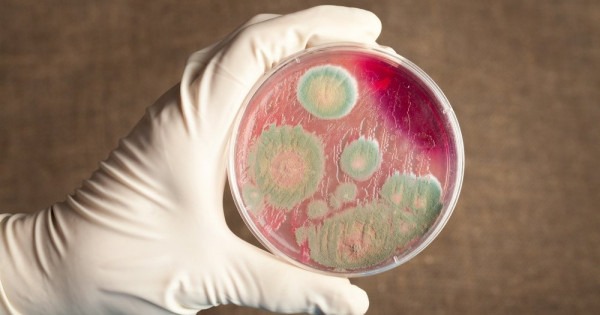

ШҚО Санитарлық-эпидемиологиялық бақылау департаменті баспасөз қызметінің мәліметі бойынша, аталмыш ауылда бірден карантин енгізілген. Ауылдың сыртында шлагбаум мен дезинфекциялық барьерлер орнатылған. Сондай-ақ ауылдан мал шығару, мал әкелу, сою мен сатуға тыйым салынған.
Ошақтар бойынша 61 байланыста болған адам анықталды.
Бүгінгі таңда инфекция жұқтырғандар толық жазылып, стационардан шығарылған. 2 қыркүйекте ауылдық округ әкімінің шешімімен карантин алынды.
Инфекция жұқтырған малдардың ошағында дезинфекция жүргізілді. Санитариялық-эпидемиологиялық қызметтің мамандары үй-үйді аралап, тексеріп шыққан.





































